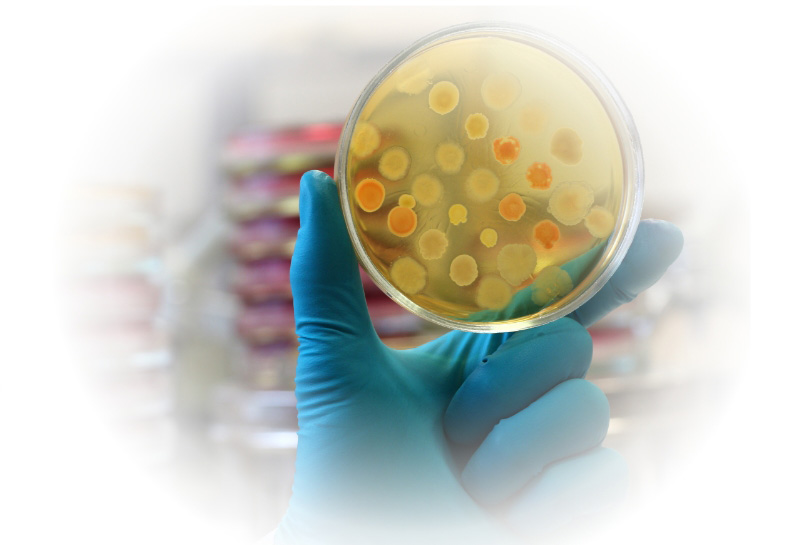
Pfizer

CLEAR_CF Study
A non-interventional study to identify in vitro
susCeptibiLity of bactErAial stRains
isolated from patients with Cystic Fibrosis in Poland.
susCeptibiLity of bactErAial stRains
isolated from patients with Cystic Fibrosis in Poland.
Non-interventional Study
Dear Sir or Madam,
We would like to invite you to participate in a multicenter, non-interventional study which aims to identify in vitro antimicrobial susceptibility of bacterial strains isolated from the respiratory tract (induced/spontaneous sputum or bronchoalveolar lavage) of patients with CF.
It is necessary to conclude an online contract in order to start the study, therefore we ask for registering and following the information on the computer screen.
After correct registration and signing the contract in electronic form, please log in data obtained in the process of creating an account.
It is necessary to conclude an online contract in order to start the study, therefore we ask for registering and following the information on the computer screen.
After correct registration and signing the contract in electronic form, please log in data obtained in the process of creating an account.
BioStat is responsible
for the comprehensive
implementation of the study.
for the comprehensive
implementation of the study.
Please direct any questions
to the Organizer's office.
to the Organizer's office.
Please complete the registration form
and participation in the study.
Registration Form and participation in the study.
Sponsor:
Pfizer Polska Sp. z o.o
Żwirki i Wigury 16B
02-092 Warszawa
Żwirki i Wigury 16B
02-092 Warszawa
Please log in with your details received
after the conclusion of the contract.
after the conclusion of the contract.
